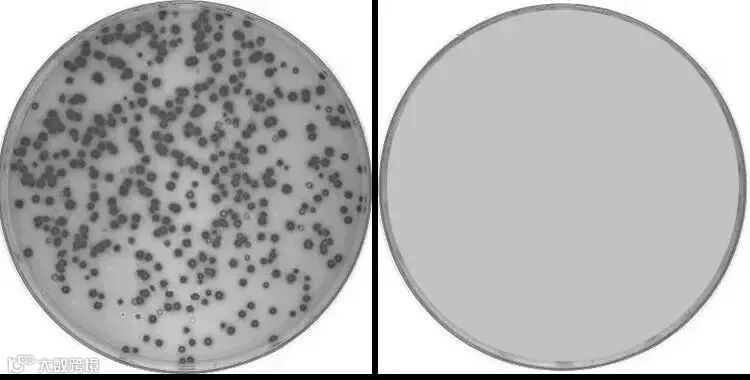

每个有气质的女生,除了五官动人之外,似乎从来离不开唇红齿白、吐气如兰这两个成语。

牙白的女生总是能让人觉得干净、整洁,牙黄真的是能毁所有,各种烟渍、茶渍、咖啡渍堆积着,颜值直接变成了负数......

除了牙黄 ,还有张口就来的口臭更是让人崩溃。嘴里仿佛住了个沼气池一样,接吻都巨尴尬!有了口臭,哪怕你10分颜值,别人对你也是0好感。

牙黄口臭除了会有损我们的形象,长时间更会威胁我们的口腔健康。严重时牙龈出血、牙菌斑、牙齿敏感等问题便会统统找上门。

注意:如果你有以上问题,那很可能你口腔里的细菌要比地球上的人还多!

临床试验证明,口腔疾病的罪魁祸首正是细菌,口臭患者肠道大肠杆菌数量比其他人群高出200倍,幽门螺杆菌数量比其他人群高出150倍!

幽门螺旋杆菌也正是现代人胃病频发的主要诱因,并且这是能致癌的细菌。

所以,拥有一个健康、干净的口腔环境真的很重要!因此选对牙膏是关键。
小编今天想给大家推荐的就是尚冠源铁皮石斛口腔膏(后统称DC口腔膏)。
它采用“中华九大仙草之首”铁皮石斛,能抑制口腔内 99%的有害细菌,给你带来持久清新口气,亮白牙齿,并且还能缓解溃疡,焕新口腔。

因为效果好还受到老戏骨罗家英老师、央视名嘴赵忠祥老师的推荐,让你用的安心、放心,收获健康好牙口!

官方认证Yi用级口腔膏
能抑制99%细菌
细心的仙女一定都看到这支牙膏名字叫口腔膏,而不是单纯的牙膏,其实这是有大学问的!
我们普通的牙膏主要就是牙齿清洁,要求标准一般,效果也一般;而DC口腔膏均按照药品级标准生产,所有原料均选用医药级原料,更是获得了“消”字号认证,可以走入yi保药房、yi院等渠道!

所以当你看到“消字号”,你就知道这是一个真正意义上能解决口腔、牙齿问题的口腔膏!

之所以能抑菌99%还得靠它其中的中药成分,中华九大仙草之首——铁皮石斛,它是中华几千年的名贵中药材。

里面含有:活性石斛多糖,对幽门螺杆菌种有显著的抑制作用,对于杀菌、口腔溃疡修复均有较好效果。

所以用它刷牙1次,比普通牙膏刷20次牙还干净,它能抑制口腔内99%的有害细菌,去除口臭,缓解溃疡,焕新口腔!

不仅如此,市面上的铁皮石斛多糖含量在20%-30%间,但这款牙膏采用的多糖含量高达 40.1%!

不惜成本,就是要狠狠杀菌!附上检测报告,口腔膏的抑菌效果看得见!

嘴里的有害菌没了,那烦人的口臭自然也没了,实测刷完牙9小时,嘴也是香香的!

口腔膏内还加入了费瓦湖畔的新鲜银桂,仿佛还带着尼泊尔少女的明媚,浓郁饱满却不显厚重刺激,一口清新。

不管你是老烟民还是口臭问题者,用了口腔膏,异味被连根拔起,一张口香味淡雅,气质如兰。
也因为极优秀的口腔护理效果得到了许多好评~

大黄牙变大白牙
邋遢女孩变身气质女孩
除了口臭问题,DC口腔膏还利用美国进口陶氏摩擦剂,能深入牙齿缝隙清洁牙齿污垢、黄渍和黑渍,将脏污和细菌一网打尽。

同时配以多种柔性颗粒,不损害牙釉质,还能保护牙龈,美白、去垢效果比其他牙膏好多了。

看我们的对比测试,效果一目了然:

因为蛋壳与人类牙齿的成分类似,黑斑黑点也正如牙齿上的烟、茶渍沉淀,非常适合拿来做实验。
难去的污渍、斑点都被口腔膏刷光光了,洁净力真的是强!

口腔膏另外还添加了珠光粉成分,这可是国际上认可的美白牙齿成分,坚持使用,能让你感受到洗牙级的美白效果!

当然普通黄牙都只是小儿科,口腔膏对烟渍、咖啡渍等顽固牙渍,也有非常明显的去垢效果,让你的牙齿白亮到发光~

大黄牙不见了,整个人也自信起来,大胆笑出自信光彩。

消炎抗敏、修复溃疡
恢复健康好口腔
小编同事是个终极吃货,天天不是火锅、小龙虾、就是麻辣川菜,所以三天两头长口腔溃疡,还要敏感发炎、长泡出血。

赶紧给他用了这支牙膏敷在伤患处,马上就止疼了,连续使用几天口腔溃疡就好了。

就是因为石斛具有消炎镇静的作用,能降低口腔底火,抗炎消敏,修复受损口腔细胞的同时,更润养牙釉质。

而且抑菌成分把细菌一网打尽,让牙龈炎、牙周炎通通滚蛋,强健牙根,还你拥有无菌无臭的健康好口腔!

所以用了口腔膏,不仅能除口臭、灭黄牙,还能还你健康好牙口吃嘛嘛香,三全其美,买它!买它!买它!
高颜值 味道清新好入口
有别于小作坊生产,口腔膏有十万级洁净车间认证,1300亩无公害种植试验基地,全都按国家药品生产要求精制,品质超高~

而且口腔膏的外包装不惜成本地采用了275厚度铝塑管,是食品级的软管材质,只需一眼,就脱颖而出~

挤出膏体,更是让人心动的星空颜值,带着闪闪发光的颗粒~超美的~

入口味道也很清新,有股甜味,成分安全到可以吃,家里的宝宝、孕妇也可以用哟~
这样的牙膏给自己是一份健康,给家人,是一份关怀。
现价:¥49/支,第二支半价¥73.5/2支,


















